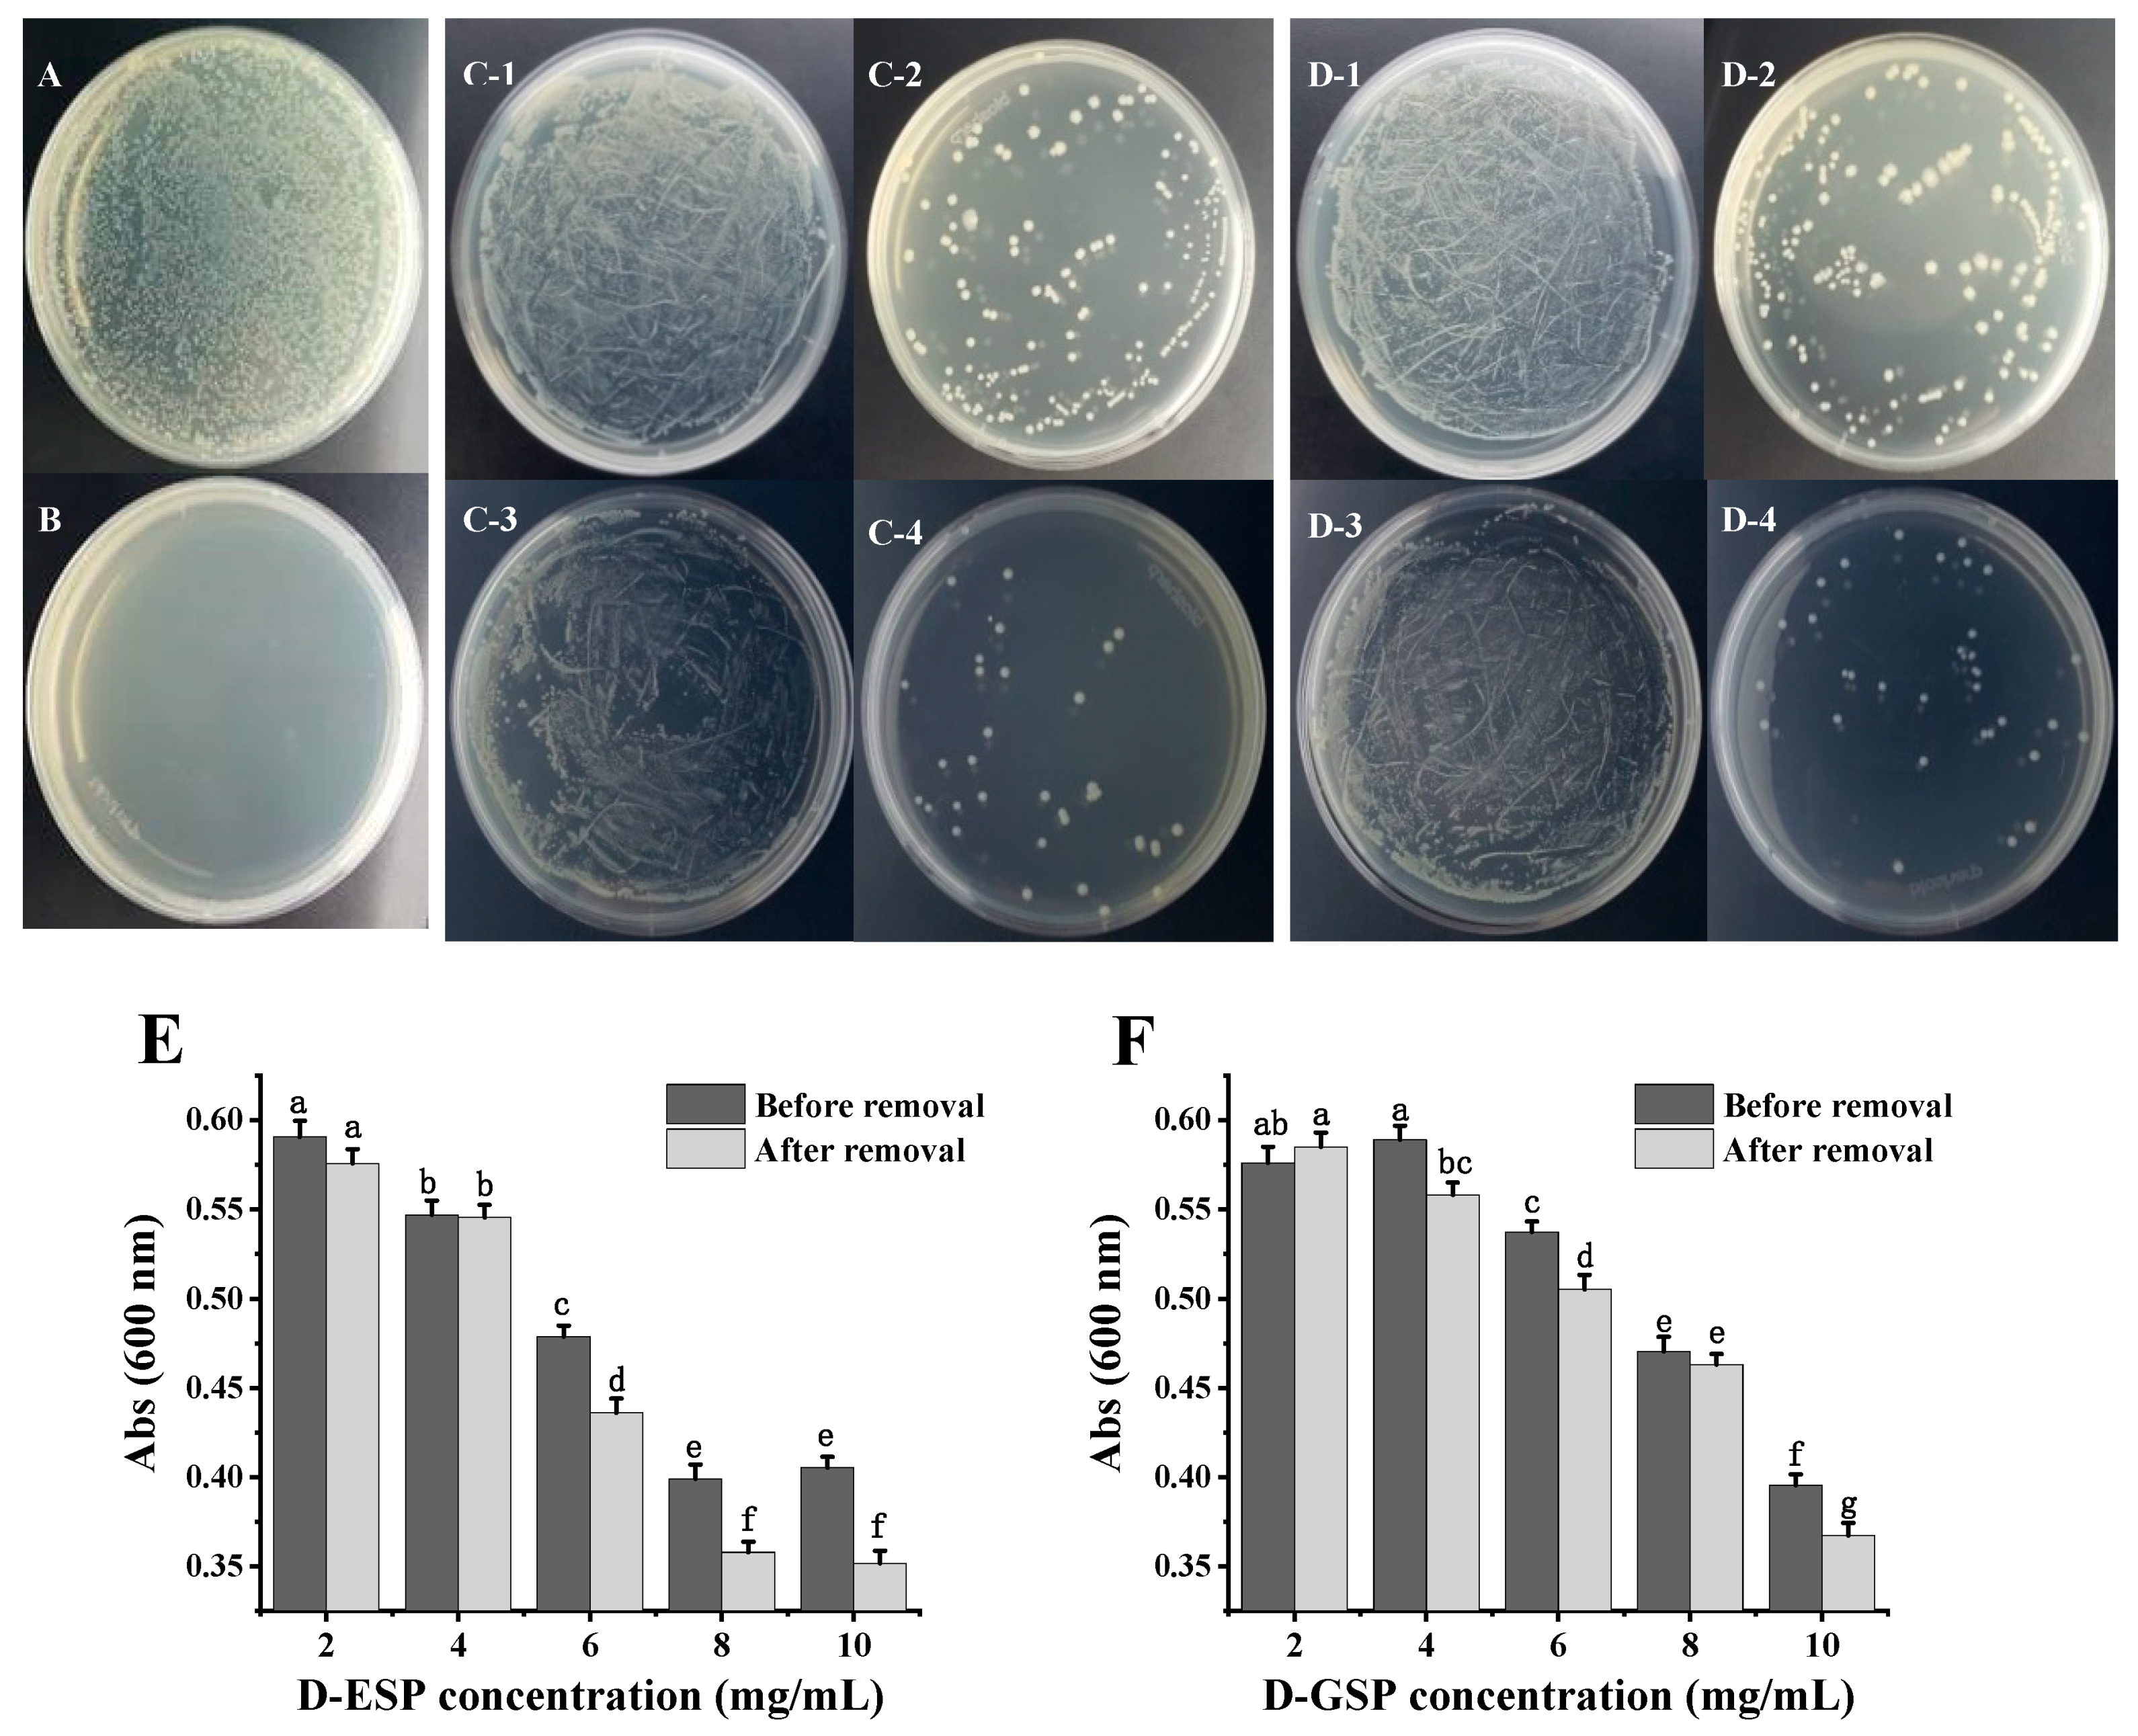

Antibacterial Activity of Sulfated Galactans from Eucheuma serra and Gracilari verrucosa against Diarrheagenic Escherichia coli via the Disruption of the Cell Membrane Structure
Abstract
1. Introduction
2. Results and Discussion
2.1. Removing the Metal Ions from Sulfated Galactans
2.2. Depolymerization of Sulfated Galactans
2.3. The Effect of Metal Ion Removal on Antimicrobial Activity
2.4. Observation of the Polysaccharides Entering the Bacterial Cells
2.5. The Effect of Depolymerized Sulfated Galactans on Cell Membrane Permeability
2.6. Analysis of the Cell Membrane Integrity
2.7. Sensitivity to Different Microorganisms
3. Materials and Methods
3.1. Chemical Reagents and Materials
3.2. The Isolation and Purification of Sulfated Galactans
3.3. The Desorption of Metal Ions from the Polysaccharides
3.4. The Depolymerization of the Sulfated Galactans
3.5. Bacterial Strains and Culture Conditions
3.6. Antibacterial Assay
3.7. MIC and MBC
3.8. Observation of the Sulfated Polysaccharides Entering the Bacterial Cells
3.8.1. Fluorescent Labeling of the Sulfated Polysaccharides
3.8.2. Fluorescence Microscope Observations
3.9. Observation of the Cell Membrane Permeability
3.10. Leakage of Intracellular Protein
3.11. The Effect of Sulfated Polysaccharides on the Growth of Different Microorganisms
3.12. Statistical Analysis
4. Conclusions
Author Contributions
Funding
Conflicts of Interest
References
- Ruan, X.; Zhang, W. Oral immunization of a live attenuated Escherichia coli strain expressing a holotoxin-structured adhesin–toxoid fusion (1FaeG-FedF-LTA2:5LTB) protected young pigs against enterotoxigenic E. coli (ETEC) infection. Vaccine 2013, 31, 1458–1463. [Google Scholar] [CrossRef]
- Walker, R.I. An assessment of enterotoxigenic Escherichia coli and Shigella vaccine candidates for infants and children. Vaccine 2015, 33, 954–965. [Google Scholar] [CrossRef]
- Zhang, H.; Xu, Y.; Zhang, Z.; You, J.; Yang, Y.; Li, X. Protective immunity of a Multivalent Vaccine Candidate against piglet diarrhea caused by enterotoxigenic Escherichia coli (ETEC) in a pig model. Vaccine 2018, 36, 723–728. [Google Scholar] [CrossRef]
- Li, S.; Qi, Y.; Chen, L.; Qu, D.; Li, Z.; Gao, K.; Chen, J.; Sun, Y. Effects of Panax ginseng polysaccharides on the gut microbiota in mice with antibiotic-associated diarrhea. Int. J. Biol. Macromol. 2019, 124, 931–937. [Google Scholar] [CrossRef]
- Ropellato, J.; Carvalho, M.M.; Ferreira, L.G.; Noseda, M.D.; Zuconelli, C.R.; Gonçalves, A.G.; Ducatti, D.R.B.; Kenski, J.C.N.; Nasato, P.L.; Winnischofer, S.M.B.; et al. Sulfated heterorhamnans from the green seaweed Gayralia oxysperma: Partial depolymerization, chemical structure and antitumor activity. Carbohydr. Polym. 2015, 117, 476–485. [Google Scholar] [CrossRef]
- Cui, M.; Wu, J.; Wang, S.; Shu, H.; Zhang, M.; Liu, K.; Liu, K. Characterization and anti-inflammatory effects of sulfated polysaccharide from the red seaweed Gelidium pacificum Okamura. Int. J. Biol. Macromol. 2019, 129, 377–385. [Google Scholar] [CrossRef]
- Yang, Y.; Liu, D.; Wu, J.; Chen, Y.; Wang, S. In vitro antioxidant activities of sulfated polysaccharide fractions extracted from Corallina officinalis. Int. J. Biol. Macromol. 2011, 49, 1031–1037. [Google Scholar] [CrossRef]
- Sanjeewa, K.K.A.; Kang, N.; Ahn, G.; Jee, Y.; Kim, Y.-T.; Jeon, Y.-J. Bioactive potentials of sulfated polysaccharides isolated from brown seaweed Sargassum spp in related to human health applications: A review. Food Hydrocoll. 2018, 81, 200–208. [Google Scholar] [CrossRef]
- Tziveleka, L.-A.; Ioannou, E.; Roussis, V. Ulvan, a bioactive marine sulphated polysaccharide as a key constituent of hybrid biomaterials: A review. Carbohydr. Polym. 2019, 218, 355–370. [Google Scholar] [CrossRef]
- Thangapandi, M.; Kumar, T. Antibacterial effect of fucoidan from Sargassum wightii against the chosen human bacterial pathogens. Int. Curr. Pharm. J. 2013, 2, 156–158. [Google Scholar]
- Liu, M.; Liu, Y.; Cao, M.; Liu, G.; Chen, Q.; Sun, L.; Chen, H. Antibacterial activity and mechanisms of depolymerized fucoidans isolated from Laminaria japonica. Carbohydr. Polym. 2017, 172, 294–305. [Google Scholar] [CrossRef]
- Pierre, G.; Sopena, V.; Juin, C.; Mastouri, A.; Graber, M.; Maugard, T. Antibacterial activity of a sulfated galactan extracted from the marine alga Chaetomorpha aerea against Staphylococcus aureus. Biotechnol. Bioproc. Eng. 2011, 16, 937–945. [Google Scholar] [CrossRef]
- Liu, B.; Liu, Q.-M.; Li, G.-L.; Sun, L.-C.; Gao, Y.-Y.; Zhang, Y.-F.; Liu, H.; Cao, M.-J.; Liu, G.-M. The anti-diarrhea activity of red algae-originated sulphated polysaccharides on ETEC-K88 infected mice. RSC Adv. 2019, 9, 2360–2370. [Google Scholar] [CrossRef]
- Liu, X.; Xia, W.; Jiang, Q.; Yu, P.; Yue, L. Chitosan oligosaccharide-N-chlorokojic acid mannich base polymer as a potential antibacterial material. Carbohydr. Polym. 2018, 182, 225–234. [Google Scholar] [CrossRef]
- Rabea, E.; Badawy, M.; Stevens, C.; Smagghe, G.; Steurbaut, W. Chitosan as antimicrobial agent: Applications and mode of action. Biomacromolecules 2003, 4, 1457–1465. [Google Scholar] [CrossRef]
- Rostand, K.S.; Esko, J.D. Microbial adherence to and invasion through proteoglycans. Infect. Immun. 1997, 65, 1–8. [Google Scholar] [CrossRef]
- Porse, H.; Rudolph, B. The seaweed hydrocolloid industry: 2016 updates, requirements, and outlook. J. Appl. Phycol. 2017, 29, 2187–2200. [Google Scholar] [CrossRef]
- Liu, Y.; Liu, W.; Wang, Y.; Ma, Y.; Huang, L.; Zou, C.; Li, D.; Cao, M.; Liu, G. Inhibitory effect of depolymerized sulfated galactans from marine red algae on the growth and adhesion of diarrheagenic Escherichia coli. Mar. Drugs 2019, 17, 694. [Google Scholar] [CrossRef]
- Paz, S.; Rubio, C.; Frias, I.; Gutierrez, A.J.; Gonzalez-Weller, D.; Martin, V.; Revert, C.; Hardisson, A. Toxic metals (Al, Cd, Pb and Hg) in the most consumed edible seaweeds in Europe. Chemosphere 2019, 218, 879–884. [Google Scholar] [CrossRef]
- Abu, R.; Jiang, Z.; Ueno, M.; Okimura, T.; Yamaguchi, K.; Oda, T. In vitro antioxidant activities of sulfated polysaccharide ascophyllan isolated from Ascophyllum nodosum. Int. J. Biol. Macromol. 2013, 59, 305–312. [Google Scholar] [CrossRef]
- Fan, M.; Sun, X.; Qian, Y.; Xu, Y.; Wang, D.; Cao, Y. Effects of metal ions in tea polysaccharides on their in vitro antioxidant activity and hypoglycemic activity. Int. J. Biol. Macromol. 2018, 113, 418–426. [Google Scholar] [CrossRef]
- Tokura, S.; Ueno, K.; Miyazaki, S.; Nishi, N. Molecular weight dependent antimicrobial activity by chitosan. Macromol. Sym. 1997, 120, 1–9. [Google Scholar] [CrossRef]
- Okafo, G.; Langridge, J.; North, S.; Organ, A.; West, A.; Morris, M.; Camilleri, P. High performance liquid chromatographic analysis of complex N-linked glycans derivatized with 2-aminoacridone. Anal. Chem. 1997, 69, 4985–4993. [Google Scholar] [CrossRef]
- He, F.; Yang, Y.; Yang, G.; Yu, L. Studies on antibacterial activity and antibacterial mechanism of a novel polysaccharide from Streptomyces virginia H03. Food Control 2010, 21, 1257–1262. [Google Scholar] [CrossRef]
- Kolsi, R.B.A.; Salah, H.B.; Jardak, N.; Chaaben, R.; Jribi, I.; Feki, A.E.; Rebai, T.; Jamoussi, K.; Allouche, N.; Blecker, C.; et al. Sulphated polysaccharide isolated from Sargassum vulgare: Characterization and hypolipidemic effects. Carbohyd. Polym. 2017, 170, 148–159. [Google Scholar] [CrossRef]
- Engel, H.; Smink, A.J.; Vanwijngaarden, L.; Keck, W. Murein-metabolizing enzymes from Escherichia coli: Existence of a second lytic transglycosylase. J. Bacteriol. 1992, 174, 6394–9403. [Google Scholar] [CrossRef]
- Zhang, Y.; Wu, Y.; Zheng, W.; Han, X.; Jiang, Y.; Hu, P.; Tang, Z.; Shi, L. The antibacterial activity and antibacterial mechanism of a polysaccharide from Cordyceps cicadae. J. Funct. Foods 2017, 38, 273–279. [Google Scholar] [CrossRef]
- Malanovic, N.; Lohner, K. Gram-positive bacterial cell envelopes: The impact on the activity of antimicrobial peptides. BBA Biomembr. 2016, 1858, 936–946. [Google Scholar] [CrossRef]
- Tang, C.; Xie, B.; Sun, Z. Antibacterial activity and mechanism of B-type oligomeric procyanidins from lotus seedpod on enterotoxigenic Escherichia coli. J. Funct. Foods 2017, 38, 454–463. [Google Scholar] [CrossRef]
- Böttcher, T.; Szamosvári, D.; Clardy, J. A repeating sulfated galactan motif resuscitates dormant Micrococcus luteus bacteria. Appl. Environ. Microbiol. 2018, 84, e00745–e00818. [Google Scholar] [CrossRef]
- Li, S.; Yang, X.; Ma, H.; Yan, J.; Guo, D. Purification, characterization and antitumor activity of polysaccharides extracted from Phellinus igniarius mycelia. Carbohydr. Polym. 2015, 133, 24–30. [Google Scholar] [CrossRef]
- Liu, Y.; Liu, Z.; Ji, B.; Wu, Y. Methods of removing heavy metals for extracting and purifying fucoidans from brown seaseeds. Food Sci. 2010, 31, 1–5. (In Chinese) [Google Scholar] [CrossRef]
- Badrinathan, S.; Shiju, T.M.; Sharon Christa, A.S.; Arya, R.; Pragasam, V. Purification and structural characterization of sulfated polysaccharide from Sargassum myriocystum and its efficacy in scavenging free radicals. Indian J. Pharm. Sci. 2012, 74, 549–555. [Google Scholar]
- Schafer, H.N.S. An improved spectrophotometric method for determination of sulfate with barium chloranilate as applied to coal ash and related materials. Anal. Chem. 1967, 39, 1719–1726. [Google Scholar] [CrossRef]
- Lin, Y.; Yang, Z.; Yang, N.; Zhang, Y.; Zhou, X.; Fan, Y. Content analysis of metal elements in sodium alginate. J. Qingdao Univ. Nat. Sci. Ed. 2018, 31, 35–39. (In Chinese) [Google Scholar]
- Chen, W.; Cheng, F.; Swing, C.J.; Xia, S.; Zhang, X. Modulation effect of core-wall ratio on the stability and antibacterial activity of cinnamaldehyde liposomes. Chem. Phys. Lipids 2019, 223, 104790. [Google Scholar] [CrossRef]
- Lin, L.; Zhu, Y.; Li, C.; Liu, L.; Surendhiran, D.; Cui, H. Antibacterial activity of PEO nanofibers incorporating polysaccharide from dandelion and its derivative. Carbohydr. Polym. 2018, 198, 225–232. [Google Scholar] [CrossRef]

| Items | Metal Elements (mg/kg) | ||||
|---|---|---|---|---|---|
| Mg | Ca | Fe | Mn | Zn | |
| ESP | 5016.2 ± 78.2 | 4307.4 ± 49.6 | 356.7 ± 12.2 | 93.3 ± 2.2 | 36.7 ± 0.5 |
| F-ESP | 2643.7 ± 53.6 | 806.4 ± 25.4 | 234.9 ± 10.6 | - | 19.5 ± 0.3 |
| GSP | 5615.4 ± 81.3 | 1690.8 ± 36.1 | 79.1 ± 3.4 | 62.8 ± 1.3 | 33.2 ± 0.3 |
| F-GSP | 3477.7 ± 62.5 | 610.2 ± 21.3 | 41.7 ± 1.7 | - | - |
| Test Items | D-ESP | D-GSP | ||
|---|---|---|---|---|
| Before Removal | After Removal | Before Removal | After Removal | |
| MIC (mg/mL) | 10.0 | 8.0 | 12.5 | 10.0 |
| MBC (mg/mL) | 25 | 12.5 | 25.0 | 25.0 |
© 2020 by the authors. Licensee MDPI, Basel, Switzerland. This article is an open access article distributed under the terms and conditions of the Creative Commons Attribution (CC BY) license (http://creativecommons.org/licenses/by/4.0/).
Share and Cite
Liu, Y.; Ma, Y.; Chen, Z.; Li, D.; Liu, W.; Huang, L.; Zou, C.; Cao, M.-J.; Liu, G.-M.; Wang, Y. Antibacterial Activity of Sulfated Galactans from Eucheuma serra and Gracilari verrucosa against Diarrheagenic Escherichia coli via the Disruption of the Cell Membrane Structure. Mar. Drugs 2020, 18, 397. https://doi.org/10.3390/md18080397
Liu Y, Ma Y, Chen Z, Li D, Liu W, Huang L, Zou C, Cao M-J, Liu G-M, Wang Y. Antibacterial Activity of Sulfated Galactans from Eucheuma serra and Gracilari verrucosa against Diarrheagenic Escherichia coli via the Disruption of the Cell Membrane Structure. Marine Drugs. 2020; 18(8):397. https://doi.org/10.3390/md18080397
Chicago/Turabian StyleLiu, Yixiang, Yu Ma, Zhaohua Chen, Donghui Li, Wenqiang Liu, Ling Huang, Chao Zou, Min-Jie Cao, Guang-Ming Liu, and Yanbo Wang. 2020. "Antibacterial Activity of Sulfated Galactans from Eucheuma serra and Gracilari verrucosa against Diarrheagenic Escherichia coli via the Disruption of the Cell Membrane Structure" Marine Drugs 18, no. 8: 397. https://doi.org/10.3390/md18080397
APA StyleLiu, Y., Ma, Y., Chen, Z., Li, D., Liu, W., Huang, L., Zou, C., Cao, M.-J., Liu, G.-M., & Wang, Y. (2020). Antibacterial Activity of Sulfated Galactans from Eucheuma serra and Gracilari verrucosa against Diarrheagenic Escherichia coli via the Disruption of the Cell Membrane Structure. Marine Drugs, 18(8), 397. https://doi.org/10.3390/md18080397

